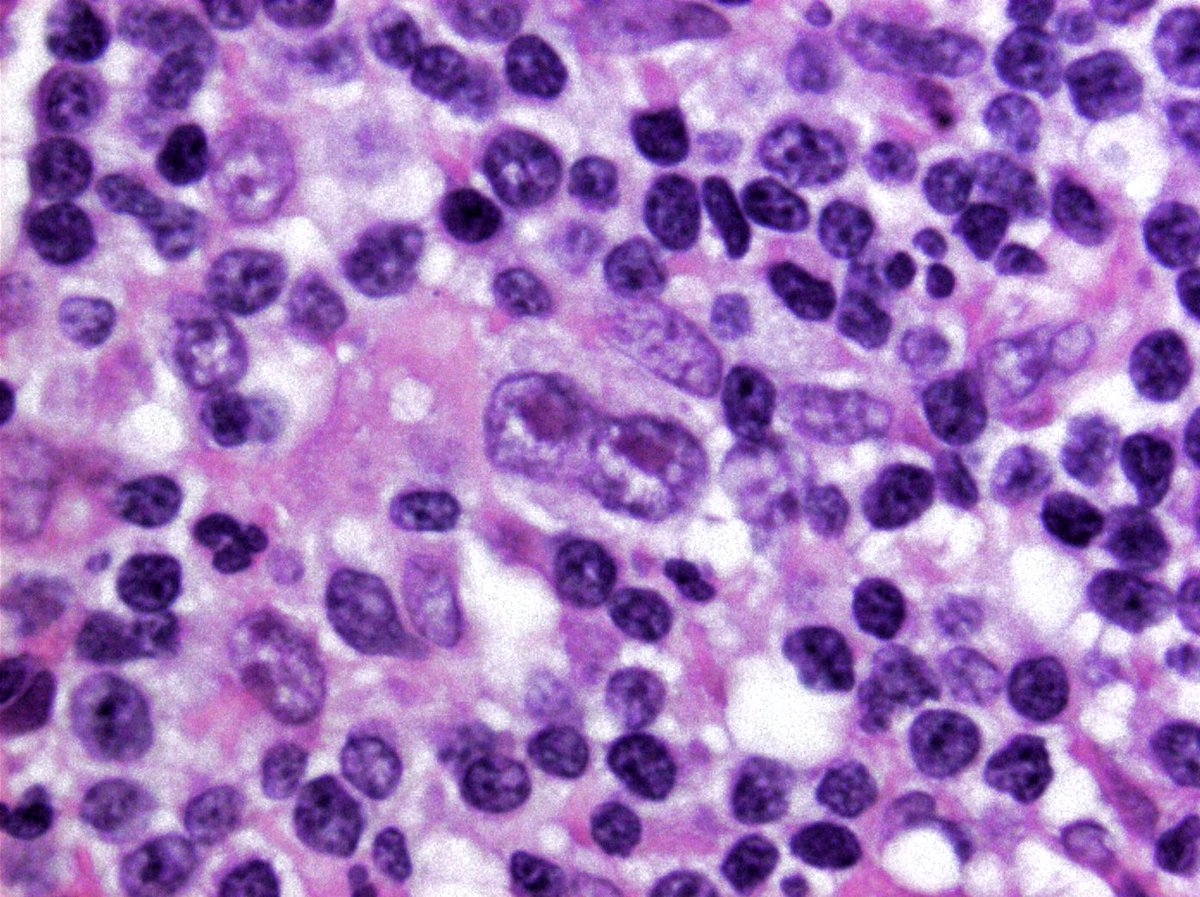
hemepathguy's tweet image. #hemepath Hodgkin cell is looking at you!

#pathosomes Suchergebnisse
Thanks @arkanalabs for showing us how silver can effect the kidney. Associated with Dx: Argyria. #Pathosomes
What is your diagnosis in a patient with a particular “gray” appearance to their complexion? #kidneypath #pathtwitter

Nice cyto w/u and Dx of schwannoma from @USFpathology #Pathosomes #TwitterPath #Cytology #Neuropath
M/60s, 2.2cm well circumscribed soft tissue mass found during workup of L shoulder rotator cuff tear. Mass remained grossly stable for years. Patient is otherwise asymptomatic. #cytopath #histology #PathTwitter #pathology #MedTwitter



Thanks @israhkhan for the Mole! #pathology #pathosomes #MedTwitter
1. cistern formation 2. p57 negative in the villi, but positive in intervillous trophoblast (internal control). Complete mole is paternally derived and partial has maternal component, so p57 positive #pathtwitter #pathresidents



Synapto, Chromo, CD56! @PoloniaAntonio #TwitterPath #SurgPath #Pathosomes
Thanks @LaraHarikMD for sharing Carcinocarcinoma w/ MMMT features. #Pathosomes #SurgPath
71 year old with post menopausal bleeding. Endometrial Biopsy: what is your diagnosis? #GYNPATH #PathTwitter #PATHRes



Great example of pyoderma gangrenosum (PG) from @SGottesmanMD #Dermatology #TwitterPath #Pathosomes
Pyoderma Gangrenosum -Pustules that progress to Painful ulcers -Rolled violaceous or hyperpigmented borders Pathergy -fascinating phenomenon (dermal injury, from PIV 3rd pic) Dx of exclusion: special stains, tissue cultures & deepers to exclude other causes #dermpath #SilviPearls




Thanks @Hemepathguy for excellent example of a case you may order CD30, CD15, CD79a, and EBV on. #pathology #oncology #pathosomes
Thanks @DrBonita16 for this "Tricky" specimen! #pathology #pathosomes #MedTwitter #infectiousdisease
Hellow #pathtwitterfamily M always thankful to you for the beautiful cases and valuable opinions...I feel bad as I can't post such cases...Here is one from whatever I get to see under my scope @atman_ci @Venkateshgilly2 @pepeheffernan @DrGeeONE @kriyer68 @pembeoltulu

Thanks @Hemepathguy for excellent example of a case you may order CD30, CD15, CD79a, and EBV on. #pathology #oncology #pathosomes
Thanks @israhkhan for the Mole! #pathology #pathosomes #MedTwitter
1. cistern formation 2. p57 negative in the villi, but positive in intervillous trophoblast (internal control). Complete mole is paternally derived and partial has maternal component, so p57 positive #pathtwitter #pathresidents



Thanks @DrBonita16 for this "Tricky" specimen! #pathology #pathosomes #MedTwitter #infectiousdisease
Hellow #pathtwitterfamily M always thankful to you for the beautiful cases and valuable opinions...I feel bad as I can't post such cases...Here is one from whatever I get to see under my scope @atman_ci @Venkateshgilly2 @pepeheffernan @DrGeeONE @kriyer68 @pembeoltulu

Thanks @arkanalabs for showing us how silver can effect the kidney. Associated with Dx: Argyria. #Pathosomes
What is your diagnosis in a patient with a particular “gray” appearance to their complexion? #kidneypath #pathtwitter

Great example of pyoderma gangrenosum (PG) from @SGottesmanMD #Dermatology #TwitterPath #Pathosomes
Pyoderma Gangrenosum -Pustules that progress to Painful ulcers -Rolled violaceous or hyperpigmented borders Pathergy -fascinating phenomenon (dermal injury, from PIV 3rd pic) Dx of exclusion: special stains, tissue cultures & deepers to exclude other causes #dermpath #SilviPearls




Thanks @LaraHarikMD for sharing Carcinocarcinoma w/ MMMT features. #Pathosomes #SurgPath
71 year old with post menopausal bleeding. Endometrial Biopsy: what is your diagnosis? #GYNPATH #PathTwitter #PATHRes



Nice cyto w/u and Dx of schwannoma from @USFpathology #Pathosomes #TwitterPath #Cytology #Neuropath
M/60s, 2.2cm well circumscribed soft tissue mass found during workup of L shoulder rotator cuff tear. Mass remained grossly stable for years. Patient is otherwise asymptomatic. #cytopath #histology #PathTwitter #pathology #MedTwitter



Something went wrong.
Something went wrong.
United States Trends
- 1. Good Tuesday N/A
- 2. Moses Moody N/A
- 3. Hannah Montana N/A
- 4. #QG603 N/A
- 5. Patrick Bateman N/A
- 6. #WWERaw N/A
- 7. Taco Tuesday N/A
- 8. Godzilla N/A
- 9. #FueraOriana N/A
- 10. #ENHYPEN_ALWAYS_7 N/A
- 11. #Daredevil N/A
- 12. Whale - Buy N/A
- 13. Star Trek N/A
- 14. American Psycho N/A
- 15. Calli N/A
- 16. God is Good N/A
- 17. Punk N/A
- 18. Claim Your Bag N/A
- 19. Valero N/A
- 20. Ends in 24h N/A